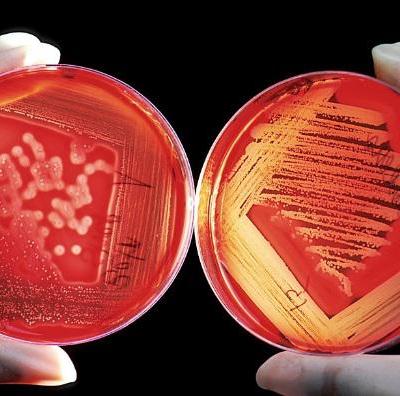

wound care
Come detergere un’ulcera cutanea efficacemente: la procedura corretta
Nel contesto di questo articolo, per detersione intenderemo l’azione del rimuovere tutto ciò che, potenzialmente, ostacola il processo di guarigione di una lesione e descriveremo la procedura e il met…
Apparato tegumentario: anatomia della cute e dei suoi annessi cutanei
L’apparato tegumentario, la cute e i suoi annessi: come sono fatti e a cosa servono? In questo articolo spiegheremo in modo semplice e completo com’è davvero fatto il nostro vestito sotto i nostri ind…
Woundcare e Telenursing: quale relazione possibile?
di Gaetano Romigi Epidemiologia In ambito sanitario il problema della gestione delle lesioni cutanee sta diventando sempre più rilevante. Si stima che in Europa 1,5-2 milioni di persone abbiano una le…
Assistenza Infermieristica al Paziente con Arteriopatia Obliterante
Come assistere efficacemente il paziente con Arteriopatia Obliterante Cronica Periferica(AOCP).
Flittene: gestione e cura delle vescicole nel paziente diabetico e in quello sano
Il flittene, o anche chiamata vescicola, è la formazione di liquido sieroso, raccolto all’interno dello spazio tra l’epidermide e gli strati inferiori a causa di diversi agenti: ustioni, pressione, tr…
Ulcere vascolari: consigli, trattamento e gestione del dolore
Questo articolo, scritto dalla Dott.ssa Valeria Pisani, laureata in Biotecnologie mediche molecolari e cellulari, è tratto da Piaghedadecubito.it: un blog specializzato nella cura e il trattamento del…
Le ulcere cutanee e il microbiota: amico o nemico?
Riceviamo e segnaliamo il prossimo evento dell’AIUC (Associazione italiana ulcere cutanee – onlus) denominato UP-TO-DATE SU INFEZIONE E ULCERE NON-HEALING “Le ulcere cutanee e il microbiota: amico o n…
Il trattamento locale di una lesione cutanea: la detersione
Detergere è un atto irrinunciabile nel trattamento di una ferita acuta o cronica: rappresenta il primo passo per preparare alla guarigione il letto della ferita dell’ulcera cutanea. Per detersione si …
Ferite difficili: controversie, attualità e prospettive in un’ottica interdisciplinare
Le ‘ferite difficili’ rappresentano un problema non facilmente inquadrabile in termini di incidenza numerica nel nostro Paese. Secondo alcune stime le ulcere cutanee rappresenterebbero lo 0,4% dei ric…
La gestione del biofilm batterico per la cura delle ferite croniche
La resistenza antimicrobica che caratterizza l’attuale panorama sanitario globale, presenta anche un forte impatto nel trattamento delle ferite croniche di difficile guarigione. “I dati attuali evide…